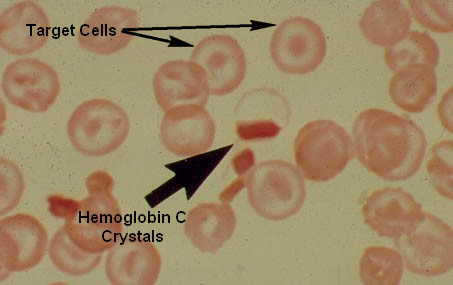
Hemoglobin-C-Crystals-and-Target-Cells

ترومبوز و خطر لخته خون: تشخیص، پیشگیری و آزمایشها
ترومبوز (Thrombosis) به وضعیتی گفته میشود که در آن لخته خونی (ترومب) در عروق خونی تشکیل میشود و میتواند جریان خون را محدود یا متوقف کند. این وضعیت ممکن است به صورت ناگهانی رخ دهد و میتواند منجر به عوارض جدی مانند سکته قلبی، سکته مغزی، آمبولی ریه و حتی مرگ شود. ترومبوز میتواند در…
اطلاعات بیشتر